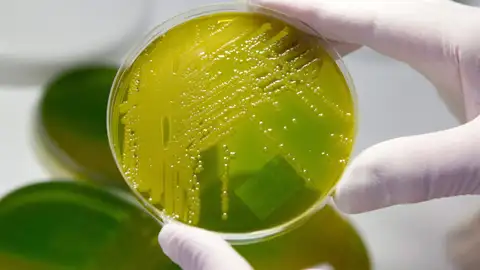
El virus de Epstein-Bar podría ser la principal causa de la esclerosis múltiple, según un macroestudio El virus de Epstein-Bar podría ser la principal causa de la esclerosis múltiple, según un macroestudio

Esclerosis múltiple
Descubren el virus que podría ser la principal causa de la esclerosis múltiple
El autor principal del estudio argumenta que este descubrimiento "podría conducir al descubrimiento de una cura para la esclerosis múltiple". Para realizar el macroestudio, se han tomado muestras de más de diez millones de reclutas de EEUU durante 20 años.
Publicidad
Durante muchos años, ha habido fuertes sospechas en la comunidad científica sobre que el virus de Epstein-Barr, conocido comúnmente como el virus del herpes humano, podría ser una de las principales causas de la esclerosis múltiple. Unos investigadores de la Universidad de Harvard han revelado un macroestudio que respalda la teoría de Epstein-Barr.
La esclerosis múltiple (EM) es una enfermedad progresiva que afecta a 2,8 millones de personas en el mundo. No existe una cura definitiva para la enfermedad. En España sufren de esclerosis múltiple unas 47.000 personas. El estudio ha sido publicado en la revista 'Science', los investigadores han tomado los datos de más de diez millones de reclutas estadounidenses desde 1993 hasta 2013, 955 de ellos fueron diagnosticados de esclerosis múltiple.
Un descubrimiento que arroja luz a una enfermedad sin respuestas
El virus de Epstein-Barr (EBV), comúnmente conocido como la 'enfermedad del beso', es un virus que infecta a la mayoría de adolescentes y permanece latente en las células B durante el resto del ciclo vital. Desde Harvard indican que ha sido complejo establecer una relación causal entre el virus y la enfermedad porque el Epstein-Barr infecta aproximadamente al 95 % de los adultos.
"La hipótesis de que el EBV causa la EM ha sido investigada por nuestro grupo y por otros durante varios años, pero este es el primer estudio que brinda evidencia convincente de causalidad", dijo Alberto Ascherio , profesor de epidemiología y nutrición en la Harvard Chan School y autor principal del estudio.
"Podría conducir al descubrimiento de una cura para la esclerosis múltiple"
El equipo de la investigación analizó muestras de suero tomadas cada dos años por el Ejército y determinó la relación entre la infección por Epstein-Barr y la aparición de esclerosis múltiple durante el periodo de servicio. Afirman que el riesgo de desarrollar esclerosis múltiple aumenta 32 veces después de la infección por EBV. Los resultados del macroestudio sugieren que el virus del herpes es la principal causa de la esclerosis múltiple.
"Este es un gran paso porque sugiere que la mayoría de los casos de esclerosis múltiple podrían prevenirse al detener la infección por Epstein-Barr, y que enfocarse en el EBV podría conducir al descubrimiento de una cura para la EM", afirma Ascherio.
El autor principal del estudio exclama que una vacuna contra el Epstein-Barr o el ataque al virus con antivirales específicos podría, en última instancia, prevenir o curar la esclerosis múltiple.
Publicidad